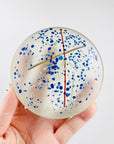

Signed vintage satin art glass paperweight
9.5cm x 2cm, in good vintage condition.
We partially subsidise your shipping costs, we charge $10.00 flat rate per order for all domestic purchases Australia-wide. International shipping will be calculated automatically by our shipping partner at checkout, if you need to bulk ship int'l please email info@glassetc.shop for more details. We will carefully package the item/s to ensure shipping quality with insurance coverage for the full price you paid for the item. In the event that the item arrives damaged or broken, you must email us 1 photo of the shipping label on the package, 1 photo of the packaging inside and 1 photo of the broken item, upon our receipt of the photos that are evidence of loss/breakage, we will issue a full refund to the orignal method of purchase. Please contact our store if you need further information about shipping.